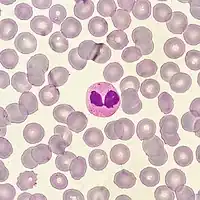

Granulócito eosinófilo
Granulócitos eosinófilos, geralmente chamados de eosinófilos (ou, menos comumente, acidófilos), são células do sistema imune responsáveis pela ação contra parasitas multicelulares e certas infecções nos vertebrados. Junto com os mastócitos, também controlam mecanismos associados com a alergia e asma. Desenvolvem-se na medula óssea (hematopoiese) antes de migrar para o sangue periférico.
Tais células são eosinofílicas (possuem "afinidade por ácido") - normalmente transparentes, aparecem de cor vermelho-tijolo após coloração com a eosina, um corante vermelho e ácido. A coloração fica concentrada em pequenos grânulos no citoplasma celular, que contêm vários mediadores químicos, como a histamina e proteínas como a peroxidase de eosinófilos, ribonuclease (RNase), desoxirribonucleases, lipase, plasminogênio e a proteína básica maior (MBP). Estes mediadores são liberados por um processo chamado desgranulação após a ativação do eosinófilo, e são tóxicos para os tecidos do parasita e hospedeiro.
Em indivíduos normais, eosinófilos constituem cerca de 1-6% das células brancas do sangue, e têm cerca de 12-17 micrômetros de tamanho. Em condições normais são encontrados na medula óssea, na junção entre o córtex e a medula do timo, no trato gastrointestinal, ovário, útero, baço e linfonodos, mas não em órgãos como o pulmão, pele e esôfago. A presença de eosinófilos no último desses órgãos está associado a algumas doenças. Eosinófilos persistem na circulação por 8-12 horas, e podem sobreviver nos tecidos por um período adicional de 8-12 dias, na ausência de estimulação.
Morfologia Celular
Quando visualizadas no esfregaço do sangue periférico, os eosinófilos apresentam tamanho que varia entre 12-17 µm. Estas células apresentam um núcleo bilobulado[1] muito evidente quando observado por microscopia de luz. O citoplasma do eosinófilo é repleto de grânulos, sendo essa a principal característica para sua identificação. Outras organelas como mitocôndrias, retículo endoplasmático e complexo de Golgi são pouco desenvolvidas.[1]
Os grânulos citoplasmáticos do eosinófilo apresentam uma morfologia única.[2] Possuem em sua região mais interna um núcleo cristaloide, que pela microscopia eletrônica de transmissão se mostra geralmente bastante escurecido (elétron-denso). O principal componente do cristaloide é a proteína básica maior (MBP), rica em arginina, que constitui 50% das proteínas do grânulo e é responsável por sua acidofilia. Este núcleo cristalóide está rodeado por uma matriz geralmente mais clara (elétron-lúcida).[1]
Desenvolvimento, migração e ativação
_diagram_pt.svg.png.webp)
Eosinófilos desenvolvem-se e amadurecem na medula óssea. Diferenciam-se a partir de células precursoras mielóides em resposta às citocinas interleucina 3 (IL-3), interleucina 5 (IL-5), e fator de estímulo de colônias de granulócitos macrófagos (GM-CSF). Eosinófilos produzem e armazenam muitas proteínas do grânulo secundário antes da sua saída da medula óssea. Após a maturação, circulam no sangue e migram para locais de inflamação nos tecidos, ou para os locais de infecção por helmintos, em resposta a citocinas como CCL11 (eotaxina-1), CCL24 (eotaxina-2), CCL5 (RANTES), e leucotrienos como o leucotrieno B4 (LTB4).
Nos locais de infecção são ativados por citocinas tipo 2 e por um subconjunto específico das células T helper (Th2).
Se desenvolvem em aproximadamente uma semana, circulam com uma meia vida de 8 a 18 horas e se aderem nos tecidos (principalmente mucosas), ondem vivem por várias semanas. Para cada 1 eosinófilo circulante existe cerca de 300 a 500 nos tecidos.
Função
Na sequência de ativação dos eosinófilos, suas funções efetoras incluem a produção de:
- proteínas catiônicas do grânulo e a sua libertação pela desgranulação.
- espécies reativas de oxigênio, como superóxido, peróxido e ácido hipobromoso (que é preferencialmente produzido pela peroxidase de eosinófilos).
- Mediadores lipídicos como os leucotrienos pertencentes à família dos eicosanóides (por exemplo, LTC4, LTD4, LTE4), prostaglandinas (eg, PGE2) e enzimas, como a elastase.
- Fatores de crescimento como o TGF beta, VEGF e PDGF. [9] [10]
- Citocinas como a IL-1, IL-2, IL-4, IL-5, IL-6, IL-8, IL-13 e TNF alfa [11].
Além disso, os eosinófilos desempenham um papel na luta contra as infecções virais, o que é evidente a partir da abundância de RNAses que eles contêm dentro de seus grânulos, e na remoção de fibrina durante a inflamação. Juntamente com basófilos e mastócitos, são importantes mediadores das respostas alérgicas e patogênese da asma e estão associados com a severidade da doença. Eles lutam também contra a colonização de helmintos (verme) e podem estar ligeiramente em número elevado na presença de certos parasitas. Os eosinófilos também estão envolvidos em muitos outros processos biológicos, incluindo o desenvolvimento pós-púberes da glândula mamária, a rejeição de enxertos e neoplasias. Eles também têm sido recentemente implicados na apresentação de antígenos às células T.
Proteínas dos grânulos
Seguindo a ativação de um estímulo imunológico, eosinófilos sofrem desgranulação para liberar uma série de grânulos citotóxicos: proteínas catiônicas que são capazes de induzir lesão e disfunção tecidual. Estes incluem:
- Proteína básica maior (MBP)
- Proteína catiônica eosinofílica (ECP)
- Peroxidase eosinofílica (EPO)
- Neurotoxina derivada de eosinófilos (EDN)
A Proteína básica maior, a peroxidase eosinofílica e a proteína catiônica eosinofílica são tóxicas para muitos tecidos [3]. A proteína catiônica eosinofílica e a neurotoxina derivada de eosinófilos são ribonucleases com atividade antiviral [4]. A proteína básica maior induz a desgranulação de mastócitos e basófilos e está implicada na remodelação do nervo periférico [5][6]. A proteína catiônica eosinofílica cria poros tóxicos nas membranas das células alvo, permitindo a potencial entrada de outras moléculas citotóxicas na célula [7], pode inibir a proliferação de células T, suprimir a produção de anticorpos pelas células B e induzir desgranulação por mastócitos [8]. A peroxidase eosinofílica forma espécies reativas de oxigênio e intermediários reativos de nitrogênio que promovem o estresse oxidativo no alvo, causando morte celular por apoptose ou necrose [3].
Eosinofilia
Um aumento de eosinófilos, isto é, a presença de mais de 500 eosinófilos/microlitro de sangue é chamado de eosinofilia, e é geralmente visto em pessoas com uma infestação parasitária no intestino, doença do colágeno (como a artrite reumatóide), doenças malignas tais como a doença de Hodgkin, doenças de pele extensas (como dermatite esfoliativa), doença de Addison, no epitélio escamoso do esôfago, no caso de esofagite de refluxo, a esofagite eosinofílica, e com o uso de certas drogas como a penicilina. Em 1989, suplementos contaminados com L-triptofano causaram uma forma mortal de eosinofilia conhecida como síndrome de eosinofilia-mialgia.
Os eosinófilos desempenham um papel importante na asma, uma vez que o número de eosinófilos acumulados corresponde à gravidade da reação asmática. A eosinofilia em modelos de ratos mostrou estar associada a altos níveis de interleucina-5. Além disso, as biópsias brônquicas da mucosa realizadas em pacientes com doenças como a asma têm níveis mais altos de interleucina-5, levando a níveis mais altos de eosinófilos. A infiltração de eosinófilos nessas altas concentrações causa uma reação inflamatória. Isso leva a remodelação das vias aéreas e dificuldade em respirar.[9]
Eosinófilos também podem causar danos nos tecidos nos pulmões de pacientes asmáticos. São observadas altas concentrações de proteína básica maior (MBP) de eosinófilos e neurotoxina derivada de eosinófilos (EDN) que se aproximam de níveis citotóxicos em locais de desgranulação nos pulmões, bem como no escarro asmático.[9]
Referências
- JUNQUEIRA, L.C.U; CARNEIRO, J. (2008). Histologia Básica. Rio de Janeiro: Guanabara Koogan. pp. 244–226
- Spencer, Lisa A.; Bonjour, Kennedy; Melo, Rossana C. N.; Weller, Peter F. (2014). «Eosinophil Secretion of Granule-Derived Cytokines». Frontiers in Immunology (em inglês). 5. ISSN 1664-3224. doi:10.3389/fimmu.2014.00496
- Rothenberg, Marc E.; Hogan, Simon P. (21 de março de 2006). «The eosinophil». Annual Review of Immunology. 24 (1): 147–174. ISSN 0732-0582. doi:10.1146/annurev.immunol.24.021605.090720
- Slifman, N. R.; Loegering, D. A.; McKean, D. J.; Gleich, G. J. (1 de novembro de 1986). «Ribonuclease activity associated with human eosinophil-derived neurotoxin and eosinophil cationic protein». Journal of Immunology (Baltimore, Md.: 1950). 137 (9): 2913–2917. ISSN 0022-1767. PMID 3760576
- Zheutlin, L. M.; Ackerman, S. J.; Gleich, G. J.; Thomas, L. L. (outubro de 1984). «Stimulation of basophil and rat mast cell histamine release by eosinophil granule-derived cationic proteins». Journal of Immunology (Baltimore, Md.: 1950). 133 (4): 2180–2185. ISSN 0022-1767. PMID 6206154
- Morgan, Ross K.; Costello, Richard W.; Durcan, Niamh; Kingham, Paul J.; Gleich, Gerald J.; McLean, W. Graham; Walsh, Marie-Therese (1 de agosto de 2005). «Diverse Effects of Eosinophil Cationic Granule Proteins on IMR-32 Nerve Cell Signaling and Survival». American Journal of Respiratory Cell and Molecular Biology. 33 (2): 169–177. ISSN 1044-1549. doi:10.1165/rcmb.2005-0056OC
- Cohn, Zanvil A.; Per Venge; Peterson, Christer G. B.; Young, John Ding-E. (junho de 1986). «Mechanism of membrane damage mediated by human eosinophil cationic protein». Nature (em inglês). 321 (6070): 613–616. ISSN 1476-4687. doi:10.1038/321613a0
- Venge; Byström; Carlson; Håkansson; Karawacjzyk; Peterson; Sevéus; Trulson (1999). «Eosinophil cationic protein (ECP): molecular and biological properties and the use of ECP as a marker of eosinophil activation in disease». Clinical & Experimental Allergy (em inglês). 29 (9): 1172–1186. ISSN 1365-2222. doi:10.1046/j.1365-2222.1999.00542.x
- Sanderson, C. J. (15 de junho de 1992). «Interleukin-5, eosinophils, and disease». Blood. 79 (12): 3101–3109. ISSN 0006-4971. PMID 1596561